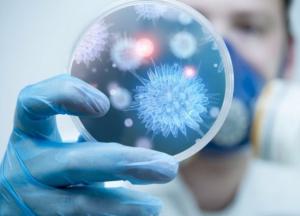
Действовать методом кнута в период коронакризиса недопустимо

Действовать методом кнута в период коронакризиса недопустимо
С понедельника 22 июня в Украине вступает в силу новая методика определения эпидемиологической ситуации в конкретном регионе, от которой зависит ужесточение карантина.
У новой методики два преимущества. Во-первых, она повышает требования к количеству тестирований. На фоне роста заболеваемости это важное и правильное решение. Во-вторых, она расширяет полномочия местных органов власти по корректированию карантинных ограничений. И при этом остается достаточно гибкой – ослабление или ужесточение ограничений происходит на локальном уровне, а не по всей стране.
Сегодня нужно добиваться улучшения эпидемиологической ситуации в каждом регионе в отдельности и во всей стране в целом. И здесь важно не только повысить количество тестирований, не только наказывать за невыполнение предписанных Кабмином мер, но и оказать людям максимальную поддержку. Особенно бизнесу, который и так сегодня дышит на ладан. Действовать методом кнута в период коронакризиса считаю недопустимым.

Ярослав Железняк розповів про свій досвід використання АІ-окулярів
Ярослав Железняк розповів про свій досвід використання АІ-окулярів
 Огляд інвертора Chisage Eris та його порівняння з легендарним Deye
Огляд інвертора Chisage Eris та його порівняння з легендарним Deye
 Зворотний процес: як правильні вправи здатні вилікувати остеохондроз, протрузії та грижі хребта
Зворотний процес: як правильні вправи здатні вилікувати остеохондроз, протрузії та грижі хребта
 15% прогресу та "скандал з Генпрокурором": Чи зірве Україна шлях до ЄС?
15% прогресу та "скандал з Генпрокурором": Чи зірве Україна шлях до ЄС?
 Крах польської підтримки: Як Україна з «жертви» стала «конкурентом» і чому Польщу охопила українофобія
Крах польської підтримки: Як Україна з «жертви» стала «конкурентом» і чому Польщу охопила українофобія
 Українські "КАБи" та "вирівнювачі": новітня зброя ефективно знищує військові об'єкти окупантів
Українські "КАБи" та "вирівнювачі": новітня зброя ефективно знищує військові об'єкти окупантів
 Hornet: Як американський дрон за €5000 став нічним жахом російської логістики на 160 км
Hornet: Як американський дрон за €5000 став нічним жахом російської логістики на 160 км
 Провальна тактика в суді: Чому відеодокази не допомогли скасувати мобілізацію на Закарпатті
Провальна тактика в суді: Чому відеодокази не допомогли скасувати мобілізацію на Закарпатті



















